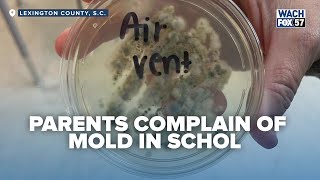
‘They Have to Close Down’: Parents Demand Action Over Mold Concerns at Charter School

Download Lagu MP3 & Video: 2 Dare County Schools Closed Over Mold Concernsrasi
Dare County Schools Board of Education Meeting: March 9, 2026
Dare County Schools - Streamed 3 months ago
Download
Dare County Schools Board of Education Meeting: June 23, 2026
Dare County Schools - Streamed 11 days ago
Download
Dare Co. Schools after-school care gets major boost through new partnership
WTKR News 3 - 8 days ago
Download
Dare County Schools Board of Education Meeting, March 10, 2025
Dare County Schools - 1 year ago
Download
Explorer Academy closed through at least next week due to mold
WSAZ NewsChannel 3 - 10 months ago
Download
‘They Have to Close Down’: Parents Demand Action Over Mold Concerns at Charter School
WACH FOX - 10 months ago
Download
Pinellas County Schools recommends closure of 2 schools, consolidation due to low enrollment
WFLA News Channel 8 - 5 months ago
Download